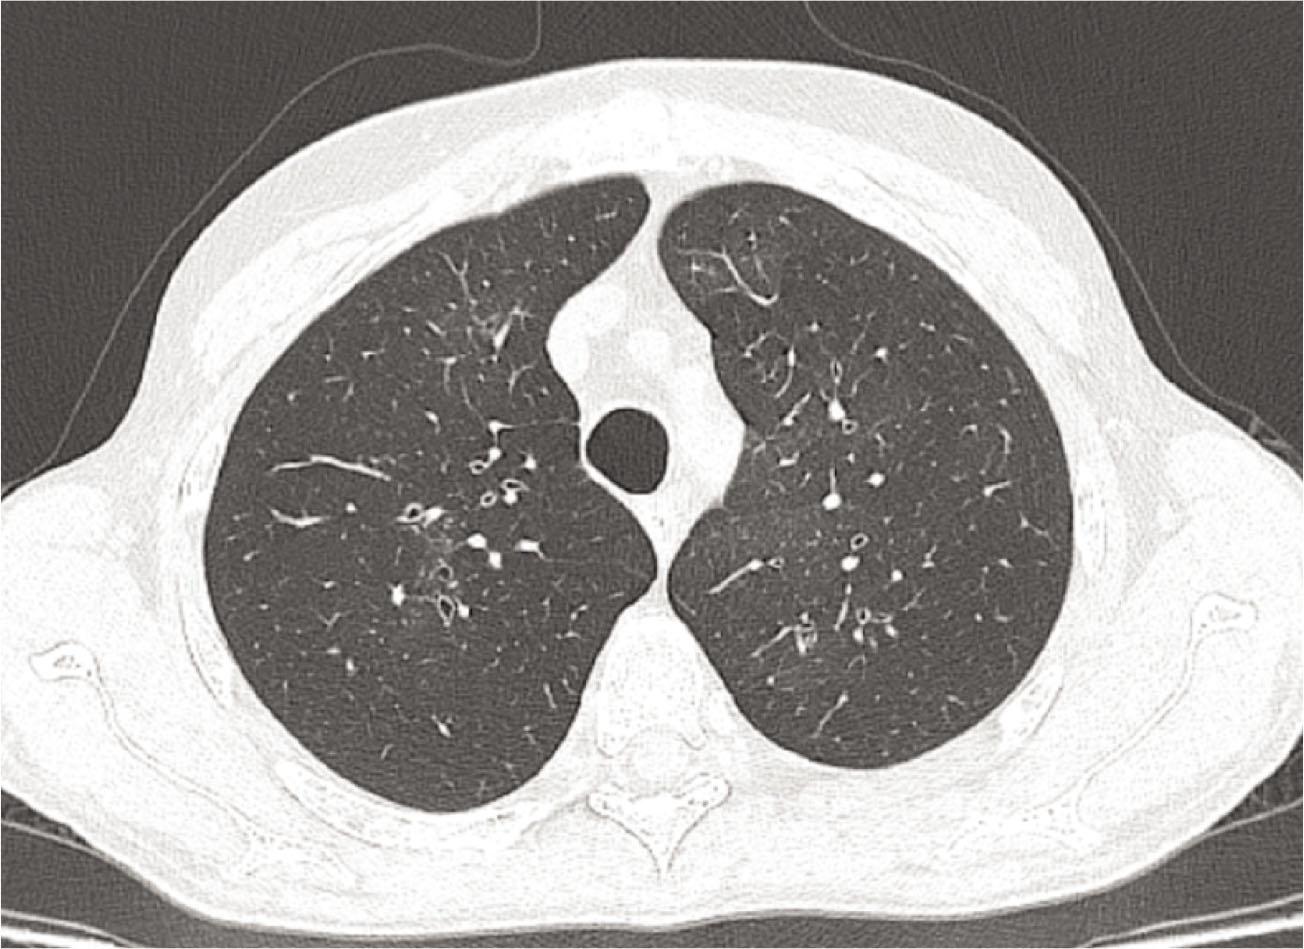

Figure 1.

Figure 2.
Figure 3A.

Summary of diagnostic investigations_
| Patient 1 | Patient 2 | Patient 3 | |
|---|---|---|---|
| HR–CT | Mosaic attenuation | Mosaic attenuation | Increased lucency, predominantly in the basal regions |
| BAL | Macrophages – 58,85% | No | No |
| Lung Biopsy | No | No | Yes |
Main characteristics of the 3 patients
| Patient 1 | Patient 2 | Patient 3 | |
|---|---|---|---|
| Age/sex | 68 / F | 33 / M | 30 / M |
| Smoking | Former smoker 20 PY | No | No |
| Exposure | No | No | No |
| Associated disease | Hypertension, Dyslipidemia | Lichen planus | No |
| Clinical | Dyspnea Dry cough | Dyspnea intermittent productive cough. | Dyspnea |
| Spirometry/FEV 1 (l/%) | Severe obstruction/0,74 (40%) | Severe fixed obstruction/0,58 (14,1%) | Severe obstruction/1,8 (42%) |
| FEV1/FVC (%) | 45% | 32,89% | 58,13% |
| FVC (l/%) | 1,64 (74%) | 1,64 (33,5%) | 3,12 (61%) |
| TLC(l/%) | MD | 8,85 (128,3%) | 8,11 (114%) |
| RV(l/%) | MD | 7,12 (398,2%) | 4,98 (281%) |
| DLCO (%) | 65% | 32,4% | 77% |
| 6MWT | significant oxygen desaturation – final SpO2 90% | significant oxygen desaturation - final SpO2 88% after 2 minutes | significant oxygen desaturation - final SpO2 88% |
Evolution of the symptoms, respiratory function and 6MWT after one month of treatment
| Patient 1- after 1 month | Patient 2 – after 2 months | Patient 3 – after one year | |
|---|---|---|---|
| Clinical | Improvement of exercitional dyspnea, Cough remission | Dyspnea intermittent productive cough. | Improvement of exercitional dyspnea |
| Spirometry/FEV1 (l) | Improved 0,85l | No improvement 0,55l | No improvement 1,51 |
| FEV1/FVC (%) | No improvement 42,9% | No improvement 29,94% | No improvement 50,38% |
| FVC (l) | Improved 1,97 | No improvement 1,64 | No improvement 2,99 |
| TLC(l) | MD | Improved 7,91 | No improvement 8 |
| RV(l) | MD | Improved 5,53l | No improvement 5 |
| DLCO (%) | Improved 71% | No improvement 30,2% | No improvement 75% |
| TM6M | Improved – no desaturation | Worse | Improved – important desaturation but with final SpO2>90% |